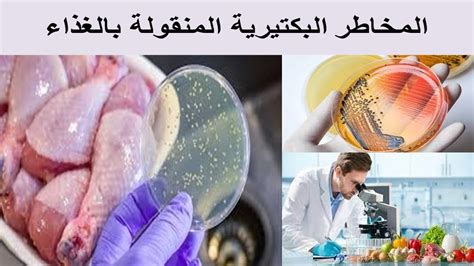

ما هي تأثيرات الزعتر على الكبد؟ يعتبر الزعتر من النباتات المستخدمة في تحنيط الجسد المصري منذ القدم. كما استخدم الإغريق الزعتر كبخور للمعابد وأضفوه إلى مياه الحمامات، وكان الرومان يستخدمونه كنكهة للجبن والكحول.
كما استخدمه الرومان لعلاج الكآبة، كما يستخدم لعلاج أمراض الجهاز التنفسي وحالاتها المختلفة، وتستخدم أوراق الزعتر لتحضيره في مشروبات كالشاي، كما يستخدم في الطبخ، كما يستخدم في الزيت مثل يستخدم مستخلص الزعتر، والزعتر له استخدامات متنوعة.
مثل إضافة رائحة الصابون، وهو أيضًا مزيل للعرق، ويستخدم كمطهر، كما أنه يطرد الحشرات.
جدول المحتويات
- أضرار الزعتر والتحذيرات من استخدامه
- الأطفال
- النساء الحوامل والمرضعات
- اضطرابات النزيف
- للحالات الحساسة لبعض الهرمونات
- جراحة:
- فوائد أخرى للزعتر
- يعالج الزعتر ارتفاع ضغط الدم
- الزعتر يتحكم في السعال
- تقوية جهاز المناعة
- محاربة الالتهابات البكتيرية المنقولة بالغذاء
- يعمل الزعتر على التخلص من الحشرات
- ويحسن المزاج
- يعمل الزعتر على استقرار زيوت الطعام
أضرار الزعتر والتحذيرات من استخدامه

يعتبر الزعتر آمنًا عند استخدامه بكميات معقولة ومناسبة وآمن أيضًا عند استخدامه كعلاج ودواء لفترة قصيرة من الوقت، إلا أنه يسبب بعض الاضطرابات في الجهاز الهضمي ويعتبر زيت الزعتر آمنًا على الجلد.
ولكنه يسبب تهيج الجلد عند بعض الناس، كما يشير إلى أنه لا توجد معلومات كافية عن عدم استخدام الزعتر وزيته كدواء فموي ومن هنا نذكر معظم المجموعات التي يتم أخذها في الاعتبار عند استخدام الزعتر بحذر وحاجة أن نكون حذرين.
شاهدي أيضاً: ما هي فوائد مطحون الزعتر بالسمسم؟
الأطفال

فمثلاً عندما يتناول الأطفال الزعتر كمشروب فهو آمن لهم بشرط تناوله بكمية مناسبة ومعتدلة، كما أنه آمن وغير ضار لهم عند تناوله لفترات قصيرة.
أيضًا، لا توجد معلومات كافية تفيد بأن زيت الزعتر آمن للاستخدام على الجلد أو تناوله عن طريق الفم.
النساء الحوامل والمرضعات

أيضا بالنسبة للحامل والمرضع، إذا تناولته المرأة الحامل بكمية كافية، فهو غير ضار تماما، والعكس صحيح، إذا تم تناول الزعتر أكثر من المعتاد، يمكن أن يؤثر عليها بشكل كبير، لذلك ننصح الأم المرضعة والمرأة الحامل لأنهم لا يأكلون الزعتر بكميات كبيرة.
اضطرابات النزيف

يبطئ الزعتر عملية تخثر الدم. لذلك عند استخدام الزعتر على نطاق واسع، يمكن أن يزيد من خطر النزيف.
للحالات الحساسة لبعض الهرمونات

للزعتر نفس تأثير الإستروجين في الجسم، لذلك يجب التوقف عن تناول الزعتر إذا كان هذا الشخص يعاني من أعراض حالات طبية حساسة للإستروجين لأن التعرض لهرمون الاستروجين يزيد من المخاطر وأسوأ، مثل: ب- سرطان الثدي وسرطان الرحم وسرطان المبيض.
جراحة:

سبق أن ذكرنا أن الزعتر يبطئ تخثر الدم.
نظرًا لأن التدخلات الجراحية يمكن أن تؤدي إلى زيادة النزيف أثناء وبعد العملية، فإننا ننصح بعدم تناول مشروب الزعتر قبل أسبوعين من التدخلات الجراحية.
فوائد أخرى للزعتر

للزعتر العديد من الفوائد الصحية للجسم حيث يحتوي على العديد من المركبات تسمى المبيدات الحشرية مثل الثيمول ويمكن أن يعرف هذا الثيمول بأنه مادة تدمر المواد التي تضر بجسم الإنسان.
تم العثور على الثيمول في مركبات أخرى مثل كارفاكرول، الذي يمنح نشاطًا قويًا مضادًا للميكروبات، والزعتر له استخدامات وفوائد أخرى، وتشمل هذه الفوائد ما يلي:
شاهدي أيضاً: فوائد الزعتر بزيت الزيتون والسمسم
يعالج الزعتر ارتفاع ضغط الدم

- وأشارت بحث علمي في جامعة بلغراد في المنطقة الصربية إلى أن الزعتر البري يخفض ضغط الدم.
للزعتر فوائد كبيرة في الوقاية من سرطان الثدي وعلاجه:
- يقول أطباء الأورام في تركيا إن الزعتر يحفز موت خلايا سرطان الثدي.
- لذلك يمنع نمو الخلايا السرطانية في الثدي.
الزعتر يتحكم في السعال

- يستخدم الزعتر كعلاج طبيعي للسعال.
- كما أنه يساعد في تقليل المشاكل التي تحدث في الجهاز التنفسي مثل: التهاب الشعب الهوائية.
تقوية جهاز المناعة

- يتكون الزعتر أيضًا من مجموعة من الفيتامينات التي تساعد الجسم بشكل كبير في دعم جهاز المناعة.
- يوفر الزعتر أيضًا كمية لا بأس بها من هذه الفيتامينات لأنه مصدر جيد لفيتامين ج وفيتامين أ.
- كما أنه يحتوي على العديد من المعادن مثل النحاس والحديد والمنغنيز.
محاربة الالتهابات البكتيرية المنقولة بالغذاء
- عندما قام مركز أبحاث الحيوان بدراسة التأثيرات المضادة للميكروبات للعديد من الزيوت الأساسية المستخرجة من الزعتر.
- ووجدوا في نبات الزعتر أنه يعمل كمادة طبيعية تحمي الجسم من البكتيريا المنقولة التي تسبب انتقال العدوى والأمراض المختلفة.
يعمل الزعتر على التخلص من الحشرات

- يحتوي الزعتر على الثيمول الذي يستخدم في صنع العديد من المبيدات.
- كما أنه يستخدم لمهاجمة البكتيريا والفيروسات وهو أيضًا مهم جدًا للتخلص من الفئران والآفات الحيوانية.
ويحسن المزاج

- يستخدم زيت الزعتر للأغراض العطرية والطبية حيث أنه يحتوي على العديد من المركبات النشطة مثل كارفاكرول.
- لأن هذه المادة تنشط الخلايا العصبية بطريقة تزيد أو تقوي الشعور بالسعادة مع الاستخدام المنتظم للزعتر.
يعمل الزعتر على استقرار زيوت الطعام

- ومن فوائده أن الزعتر يثبت زيوت الطهي لاحتوائه على مضادات الأكسدة.
- لتحقيق استقرار واستقرار زيت عباد الشمس.
- يمنع الزعتر أيضًا تأكسد الدهون عند تحضير الطعام وتخزينه.
- نتيجة لذلك، قد تتدهور جودة الأغذية وسلامتها وقيمتها الغذائية.
انظر أيضا: ما هي فوائد عسل الزعتر؟